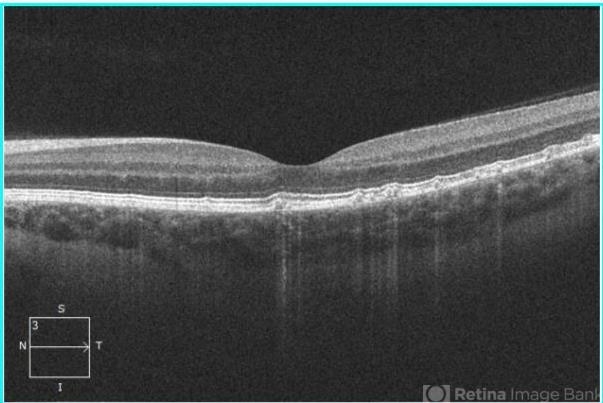

-
 By Alexandr Stepanov
By Alexandr Stepanov
- Uploaded on May 3, 2018.
- Last modified by Caroline Bozell on May 3, 2018.
- Rating
- Appears in
- Miscellaneous
- Condition/keywords
- drusen, optical coherence tomography (OCT), Bruch's membrane
- Photographer
- Alexandr Stepanov MD, PhD, FEBO, Faculty Hospital Hradec Kralove, Czech Republic
- Imaging device
- Optical coherence tomography system
- Description
- Autosomal dominant drusen of Bruch's membrane, OCT.

Initializing download.
Initializing download.










